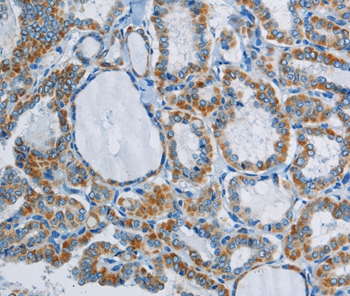
Anti-PPARGC1B Antibody

Immunohistochemistry of paraffin-embedded Human thyroid cancer tissue using PPARGC1B Polyclonal Antibody at dilution 1:30
PPARGC1B Polyclonal Antibody
E-AB-16705
Product group Antibodies
Overview
- SupplierElabscience
- Product NamePPARGC1B Polyclonal Antibody
- Delivery Days Customer12
- Applications SupplierELISA IHC
- CertificationResearch Use Only
- Concentration0.4mg/ml
- Scientific DescriptionThe protein encoded by this gene stimulates the activity of several transcription factors and nuclear receptors, including estrogen receptor alpha, nuclear respiratory factor 1, and glucocorticoid receptor. The encoded protein may be involved in fat oxidation, non-oxidative glucose metabolism, and the regulation of energy expenditure. This protein is downregulated in prediabetic and type 2 diabetes mellitus patients. Certain allelic variations in this gene increase the risk of the development of obesity. Three transcript variants encoding different isoforms have been found for this gene.
- UNSPSC12352203